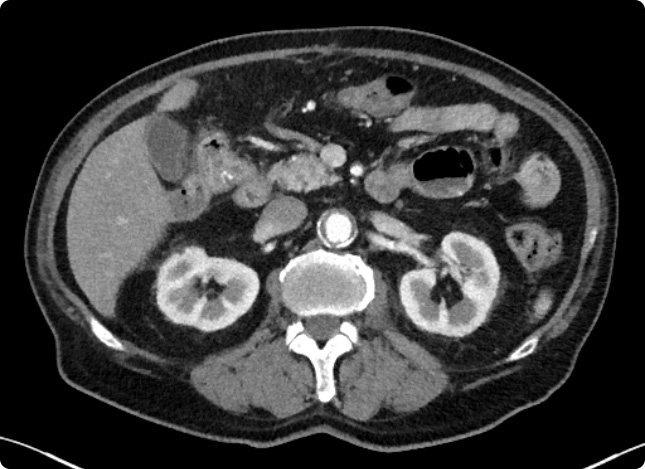

COMPUTERTOMOGRAPHIE
CT
Bei der Computertomographie (CT) werden mit Hilfe von Röntgenstrahlen und modernster Computertechnik Schnittbilder aus verschiedenen Körperabschnitten überlagerungsfrei errechnet. Moderne CTs sind keine Röhren, sondern ähneln einem großen Ring. Je nach Fragestellung dauert eine CT-Untersuchung nur wenige Minuten, der Scan selbst oft nur wenige Sekunden.
Fragen & Antworten
Wie läuft die Untersuchung ab?
Zur Untersuchung nehmen Sie auf einer Liege Platz. Dort sollten Sie bequem und ruhig liegen, sonst können die Bilder verwackelt und unscharf sein. Die Liege wird über eine Schiene in den CT-Scanner (großen Ring) gefahren. Die zu untersuchende Körperregion wird mithilfe einer rotierenden Röntgenröhre teilweise in mehreren Phasen gescannt. Manchmal werden Sie aufgefordert, für einige Sekunden die Luft anzuhalten.
Kontrastmittel
Bei vielen Fragestellungen ist es erforderlich, ein jodhaltiges Kontrastmittel über die Armvene zu verabreichen. Das Kontrastmittel „färbt“ Gefäße und Gewebe ein und ermöglicht so eine bessere Bildgebung, um beispielsweise Entzündungen oder Tumore auszuschließen.
Wichtige Infos und Fragen zur Computertomographie
- Sind Ihre Nieren und Schilddrüse gesund? Hierfür benötigen wir aktuelle Laborwerte Kreatinin und TSH (nicht älter als 3 Monate).
- Haben Sie Allergien, z. B. eine Allergie gegen jodhaltiges Kontrastmittel?
- Haben Sie Diabetes (Zuckerkrankheit)? Nehmen Sie dafür Medikamente ein? Wenn ja, welche?
- Haben Sie eine Schilddrüsenerkrankung? Wenn ja, welche?
- Besteht eine Herz-, Lungen- oder Nierenerkrankung?
- Schwangere und Kinder sollten nur im äußersten Notfall untersucht werden.
- Sind Sie unter 18 Jahren? Wenn ja, brauchen wir das Einverständnis der Erziehungsberechtigten.
In welchen Körperbereichen wird CT angewandt?
Diagnostik
- Untersuchung des Kopfes, der Nasennebenhöhle, der Schädelbasis,
knöchernes Mittel- und Innenohr - Halswirbelsäule und Halsweichteile
- Brustwirbelsäule, Lunge, Rippenfell, Mediastinum und Atemwege
- Lendenwirbelsäule, Ober- und Unterbauch, Becken, Hüfte
- Extremitäten also Schulter, Arme und Beine
Strahlenschutz
CT-Untersuchungen sind mit einer Strahlenbelastung für den Körper verbunden. Jede Computertomographie muss daher medizinisch begründet sein. Vor der CT-Untersuchung überprüfen wir, ob diese Untersuchung bei Ihnen sinnvoll und notwendig ist. Die sogenannte „rechtfertigende Indikation“ wird gestellt.